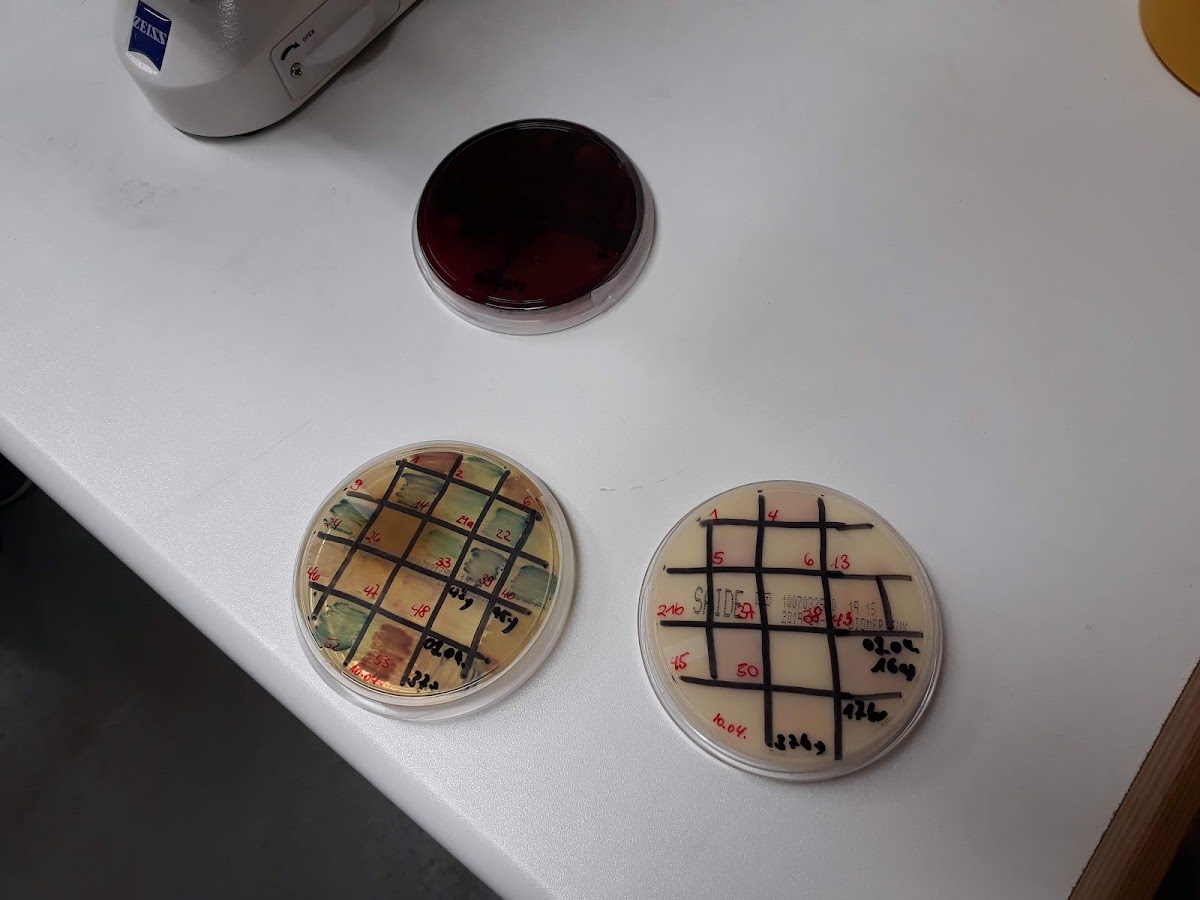

Dr. med. vet. Georg Eller Tiergesundheitszentrum Aurachsmühle
Hofheim in Unterfranken
Jetzt Angebote vergleichen!
Antwortet meist
innerhalb 24h
Über Dr. med. vet. Georg Eller Tiergesundheitszentrum Aurachsmühle
Keine detaillierte Beschreibung verfügbar.
Leistungen & Fachgebiete
Bewertungen
4.5 / 5.0
E
Erika B.
vor 7 Monaten
Ich bin sehr zufrieden in dieser Praxis, alle sehr freundlich, kann ich nur weiter empfehlen
H
Holger R.
vor 7 Monaten
Fühlen uns dort bestens aufgehoben. Die Praxis bekommt von uns volle 100🌟🙏
J
Julia 7.
vor 7 Monaten
Super liebe Ärztinnen und Personal. Wir sind immer sehr zufrieden mit der Behandlung von Oskar. Vielen lieben Dank
I
Ines F.
vor 7 Monaten
Kann diese Praxis sehr empfehlen. Sehr kompetentes und freundliches Team.
M
Madame M.
vor 7 Monaten
Für uns ist der Anfahrtsweg ein bisschen länger doch den nehmen wir gerne in Kauf. Es wurde meinem Hund immer super geholfen!!! Die Ärzte sind nett und verstehen ihren Beruf zu 1000% die Helferinnen ebenso. Das Terminmanagement läuft super und wir kommen sehr gerne- natürlich nur wenn Hündchen mal krank ist oder wenn Impfungen anstehen ☺️